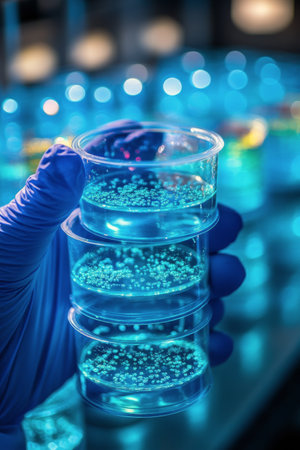

素材 - A researcher holds a petri dish with a visible culture of bacteria under a blue light in a laboratory, highlighting the details of the microorganisms as they conduct experiments late at night.
作品情報
A researcher holds a petri dish with a visible culture of bacteria under a blue light in a laboratory, highlighting the details of the microorganisms as they conduct experiments late at night.
- ID:236133046
- 作品種別:
- 作者名:olegganko
キーワード
- academic
- analysis
- bacteria
- blue
- culture
- data
- dish
- environment
- equipment
- experiment
- experimenter
- fauna
- flora
- gloves
- hand
- healthcare
- innovation
- investigation
- lab
- laboratory
- light
- medical
- method
- microbiology
- microorganisms
- microscopic
- observation
- petri
- precision
- research
- safety
- samples
- science
- scientific
- scientist
- sterile
- study
- techniques
- technology
- testing
- tools
- vivid
- weekend
類似作品
Saturn graphic,...
Lots of dirty d...
Talented chef i...
Scientist exami...
a scientist is ...
Modern satellit...
Radar
Kitchen, hands ...
earth communica...
Woman holding b...
Huge radio tele...
Close-up of a g...
Team Asian scie...
attractive hung...
Satellite TV wi...
View of radio t...
A researcher in...
Hand with a glo...
Elegant waiters...
close-up of sat...
Yellow satellit...
Nurse served su...
topography map ...
A waiter's hand...
plate in hand
Woman holding w...
Blood test in t...
Waiter with a w...
blue satellite ...
Scientist obser...
Close-up view o...
Hand in blue gl...
The silhouette ...
Satellite Anten...
Radar antenna o...
Woman in white ...
close-up of sat...
Hand in blue gl...
Chemical Labora...
modern satellit...
Female scientis...
fish seafood fa...
Hand in blue gl...
Young female de...
Chemical Labora...
A pair of satel...
dish aerial...
Hands in purple...
3d rendering gr...